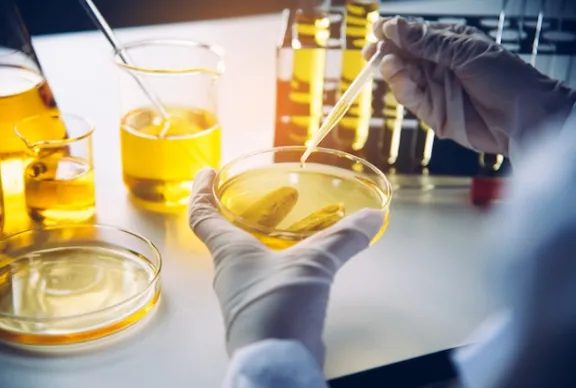
31

Laboratoire des Analyse d'huile de Transformateurs BMElectric LAB
1. Description générale
L’analyse d’huile de transformateur permet de déterminer les propriétés physico-chimiques de l’huile diélectrique afin de prévenir les contraintes électriques et thermiques, ainsi que toute contamination chimique pouvant entraîner des défaillances majeures, des dégâts catastrophiques ou une réduction significative de la durée de vie des composants.
2. Qualité et conformité des analyses
BMELECTRIC LAB vous fournit des analyses rapides et fiables, réalisées conformément aux normes internationales (IEC / ASTM), vous permettant d’identifier les anomalies dès l’apparition des premiers signes et d’agir de manière préventive.
3. Analyses spécifiques réalisées
Nos analyses spécifiques incluent :
- Analyses des gaz dissous test DGA
- Teneur en eau.
- Rigidité diélectrique test BDV.
- Facteur de dissipation tan delta et résistivité.
- Acidité et l'indice de neutralisation.
- Tension interfaciale IFT.
- Aspect / Couleur
- Teneur en PCB.
- Dérivés furaniques.
- Teneur en DBPC.
- Densité.
- Viscosité.
- Soufre corrosif.
- Stabilité à l'oxydation.
- Sédiment et boues.
- Point éclair.
- Point d'écoulement.
- Comptage de particules.
- Teneur en métaux.
- Degré de polymérisation.
4. Positionnement de BM Electric LAB
Nous souhaitons porter à votre attention que BMELECTRIC LAB représente aujourd’hui la solution la plus fiable et la plus complète en Algérie pour la réalisation des tests sur l’huile de transformateur.
5. Laboratoire local
Entièrement équipé BMELECTRIC LAB dispose d’un laboratoire moderne implanté en Algérie, capable de réaliser l’ensemble des essais standards et avancés sur l’huile de transformateur
6. Laboratoire mobile sur site
BMELECTRIC LAB met également à disposition un laboratoire mobile permettant de réaliser certains essais critiques directement sur site (DGA, teneur en eau, BDV, etc.). Cette solution garantit des résultats rapides, fiables et conformes aux normes internationales, tout en permettant aux clients de constater les résultats sans délai ni risque de détérioration des échantillons.
7. Expertise du personnel
BMELECTRIC LAB maîtrise parfaitement les normes internationales de prélèvement et d’interprétation (IEC, ASTM, etc.), assurant des résultats précis, fiables et exploitables. Fort de plus de 30 ans d’expérience dans le domaine de la haute tension et des analyses d’huile, ce personnel est capable d’interpréter les résultats et d’identifier rapidement toute anomalie susceptible d’affecter le transformateur, réduisant ainsi les risques de défaillance.
8. Capacité de recherche et d’analyse avancée
Les experts de BMELECTRIC LAB sont également des chercheurs hautement qualifiés, capables d’analyser des situations complexes et de proposer des solutions techniques adaptées, y compris dans des contextes urgents.
9. Équipements spécialisés
À titre d’exemple, l’utilisation de seringues spéciales pour l’analyse DGA permet d’éviter toute fuite de gaz, garantissant que les mesures reflètent fidèlement l’état réel de l’huile, contrairement aux seringues classiques.
10. Recommandations
Grâce à son laboratoire local complet, son laboratoire mobile, ses équipements de dernière génération et son personnel hautement qualifié, BMELECTRIC LAB constitue le choix le plus fiable et le plus efficace pour les analyses d’huile de transformateur en Algérie, alliant rapidité, précision et conformité aux normes internationales.
Nous recommandons donc vivement de faire appel à BMELECTRIC LAB pour toute analyse d’huile de transformateur nécessitant fiabilité, rapidité et expertise technique.